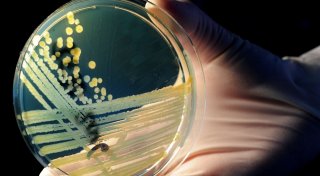

Schorfheide. Nach einem Corona-Ausbruch in einer Senioren-Residenz in Brandenburg sollen einem Medienbericht zufolge bereits acht Bewohner gestorben sein.
Insgesamt seien in der Einrichtung in Schorfheide am Werbellinsee 42 Bewohner und 15 Mitarbeiter an Covid-19 erkrankt, bestätigte das Gesundheitsamt des Landkreises Barnim dem Rundfunk Berlin-Brandenburg am Freitag.
Bewohner gut geimpft, Mitarbeiter nicht
„Es ist eine sehr ungünstige Situation in diesem Heim, weil zwar die Bewohner recht gut geimpft sind, aber die Mitarbeiter und Mitarbeiterinnen haben eine relativ geringe Impfquote", sagte Amtsärztin Heike Zander dem Radiosender Antenne Brandenburg. „In dieser Einrichtung beträgt die lediglich ungefähr 50 Prozent." Das berge ein erhöhtes Risiko, sagte Zander dem Sender, „und das hat sich jetzt auch gezeigt".
Zander zeigte sich „unglücklich" darüber, dass Impfungen in Pflegeeinrichtungen weiterhin freiwillig seien. „Das hat für mich auch was mit einer Berufseinstellung zu tun."
Drese fordert Impfpflicht in Pflege-Branche
Mecklenburg-Vorpommerns Sozialministerin Stefanie Drese (SPD) forderte nach mehreren Corona-Ausbrüchen in Pflegeeinrichtungen des Landes eine Impfpflicht für Beschäftigte in der Branche. „Es ist mein Ziel, eine Impfpflicht für Pflegepersonal rechtssicher hinzubekommen", sagte Drese dem Nachrichtenmagazin Spiegel. So sollten die Menschen geschützt werden, die besonders anfällig für eine Corona-Infektion sind. Dazu zählen Bewohner von Seniorenzentren. Die Impfpflicht muss laut Drese bundesweit im Infektionsschutzgesetz geregelt werden. Wegen juristischer Schwierigkeiten sei das in diesem Winter voraussichtlich noch nicht zu erreichen.
In den kommenden Tagen solle zunächst die Landesverordnung in Mecklenburg-Vorpommern verschärft werden. Danach müssten sich Mitarbeiter oder Bewohner von Pflegeheimen einem PCR-Test unterziehen, wenn Symptome auftreten. Zudem sollen große Versammlungen in den Heimen, die für alle zugänglich sind, verboten werden. „Es ist leider noch nicht die Zeit für große Advents- und Weihnachtsfeiern, wir müssen das untersagen", betonte Drese.
Seit Ende des Sommers habe es neun Ausbrüche in Pflegeeinrichtungen im Nordosten gegeben. In Mecklenburg-Vorpommern sind nach Angaben des Sozialministeriums 75 Prozent der Pflegekräfte geimpft.
Links zum Thema